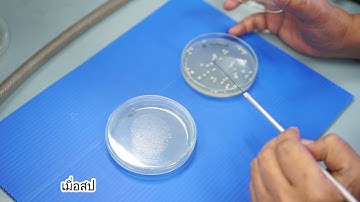
Mycology Lab Practical 2: Single spore isolation

⬇ DOWNLOAD NOW
Kalau muncul iklan pop-up, tutup lalu klik tombol kembali
Download lagu Isolating a single spore under the microscope secara gratis hanya untuk keperluan promosi. Dukung artis favorit kamu dengan membeli musik original di iTunes atau platform resmi lainnya.
 Single Spore/Monokaryotic Isolation Viewing for Clamp Connection Potential Monokaryon Isolate Part 1
Single Spore/Monokaryotic Isolation Viewing for Clamp Connection Potential Monokaryon Isolate Part 1
Mycology Lab Practical 2: Single spore isolation
Mycology Lab Practical 2: Single spore isolation
 Slide culture microscopy to identify fungus
Slide culture microscopy to identify fungus
 Fungal Microscopy: How to mount a slide, view and measure spores
Fungal Microscopy: How to mount a slide, view and measure spores
 Yeast cells and Fungal hyphae seen on Vaginal swab sample under the microscope #microscope #yeast
Yeast cells and Fungal hyphae seen on Vaginal swab sample under the microscope #microscope #yeast
 Isolating ascospores #cordyceps #mycology #freshfromthefarmfungi #microscopechallenge #agar
Isolating ascospores #cordyceps #mycology #freshfromthefarmfungi #microscopechallenge #agar
 Microscope Slide Prep: Observing Spores and Finding Clamp Connections
Microscope Slide Prep: Observing Spores and Finding Clamp Connections
 Measuring Mushroom Spores with a Microscope
Measuring Mushroom Spores with a Microscope